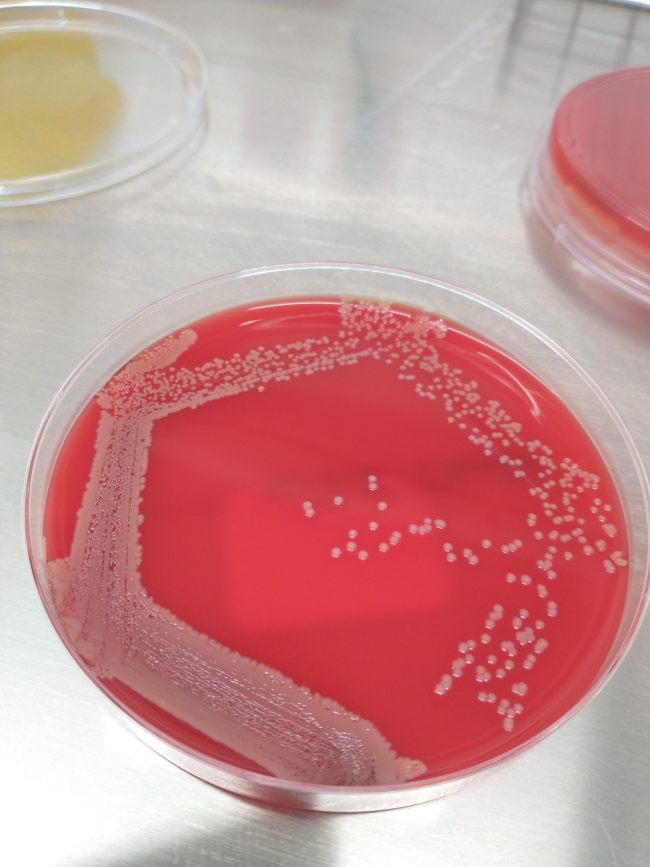
Zenit-laboratorio-pododermatitis-conejo-2

Pododermatitis de conejo
Esta semana hemos tratado un caso de pododermatitis de conejo. Es una patología en la cual se producen lesiones en las zonas de apoyo de las patas traseras, y en algunos casos avanzados podría incluso afectar las patas delanteras. Estas lesiones comienzan con una hiperplasia de la epidermis seguido de una necrosis isquémica debido a la presión de la piel que…